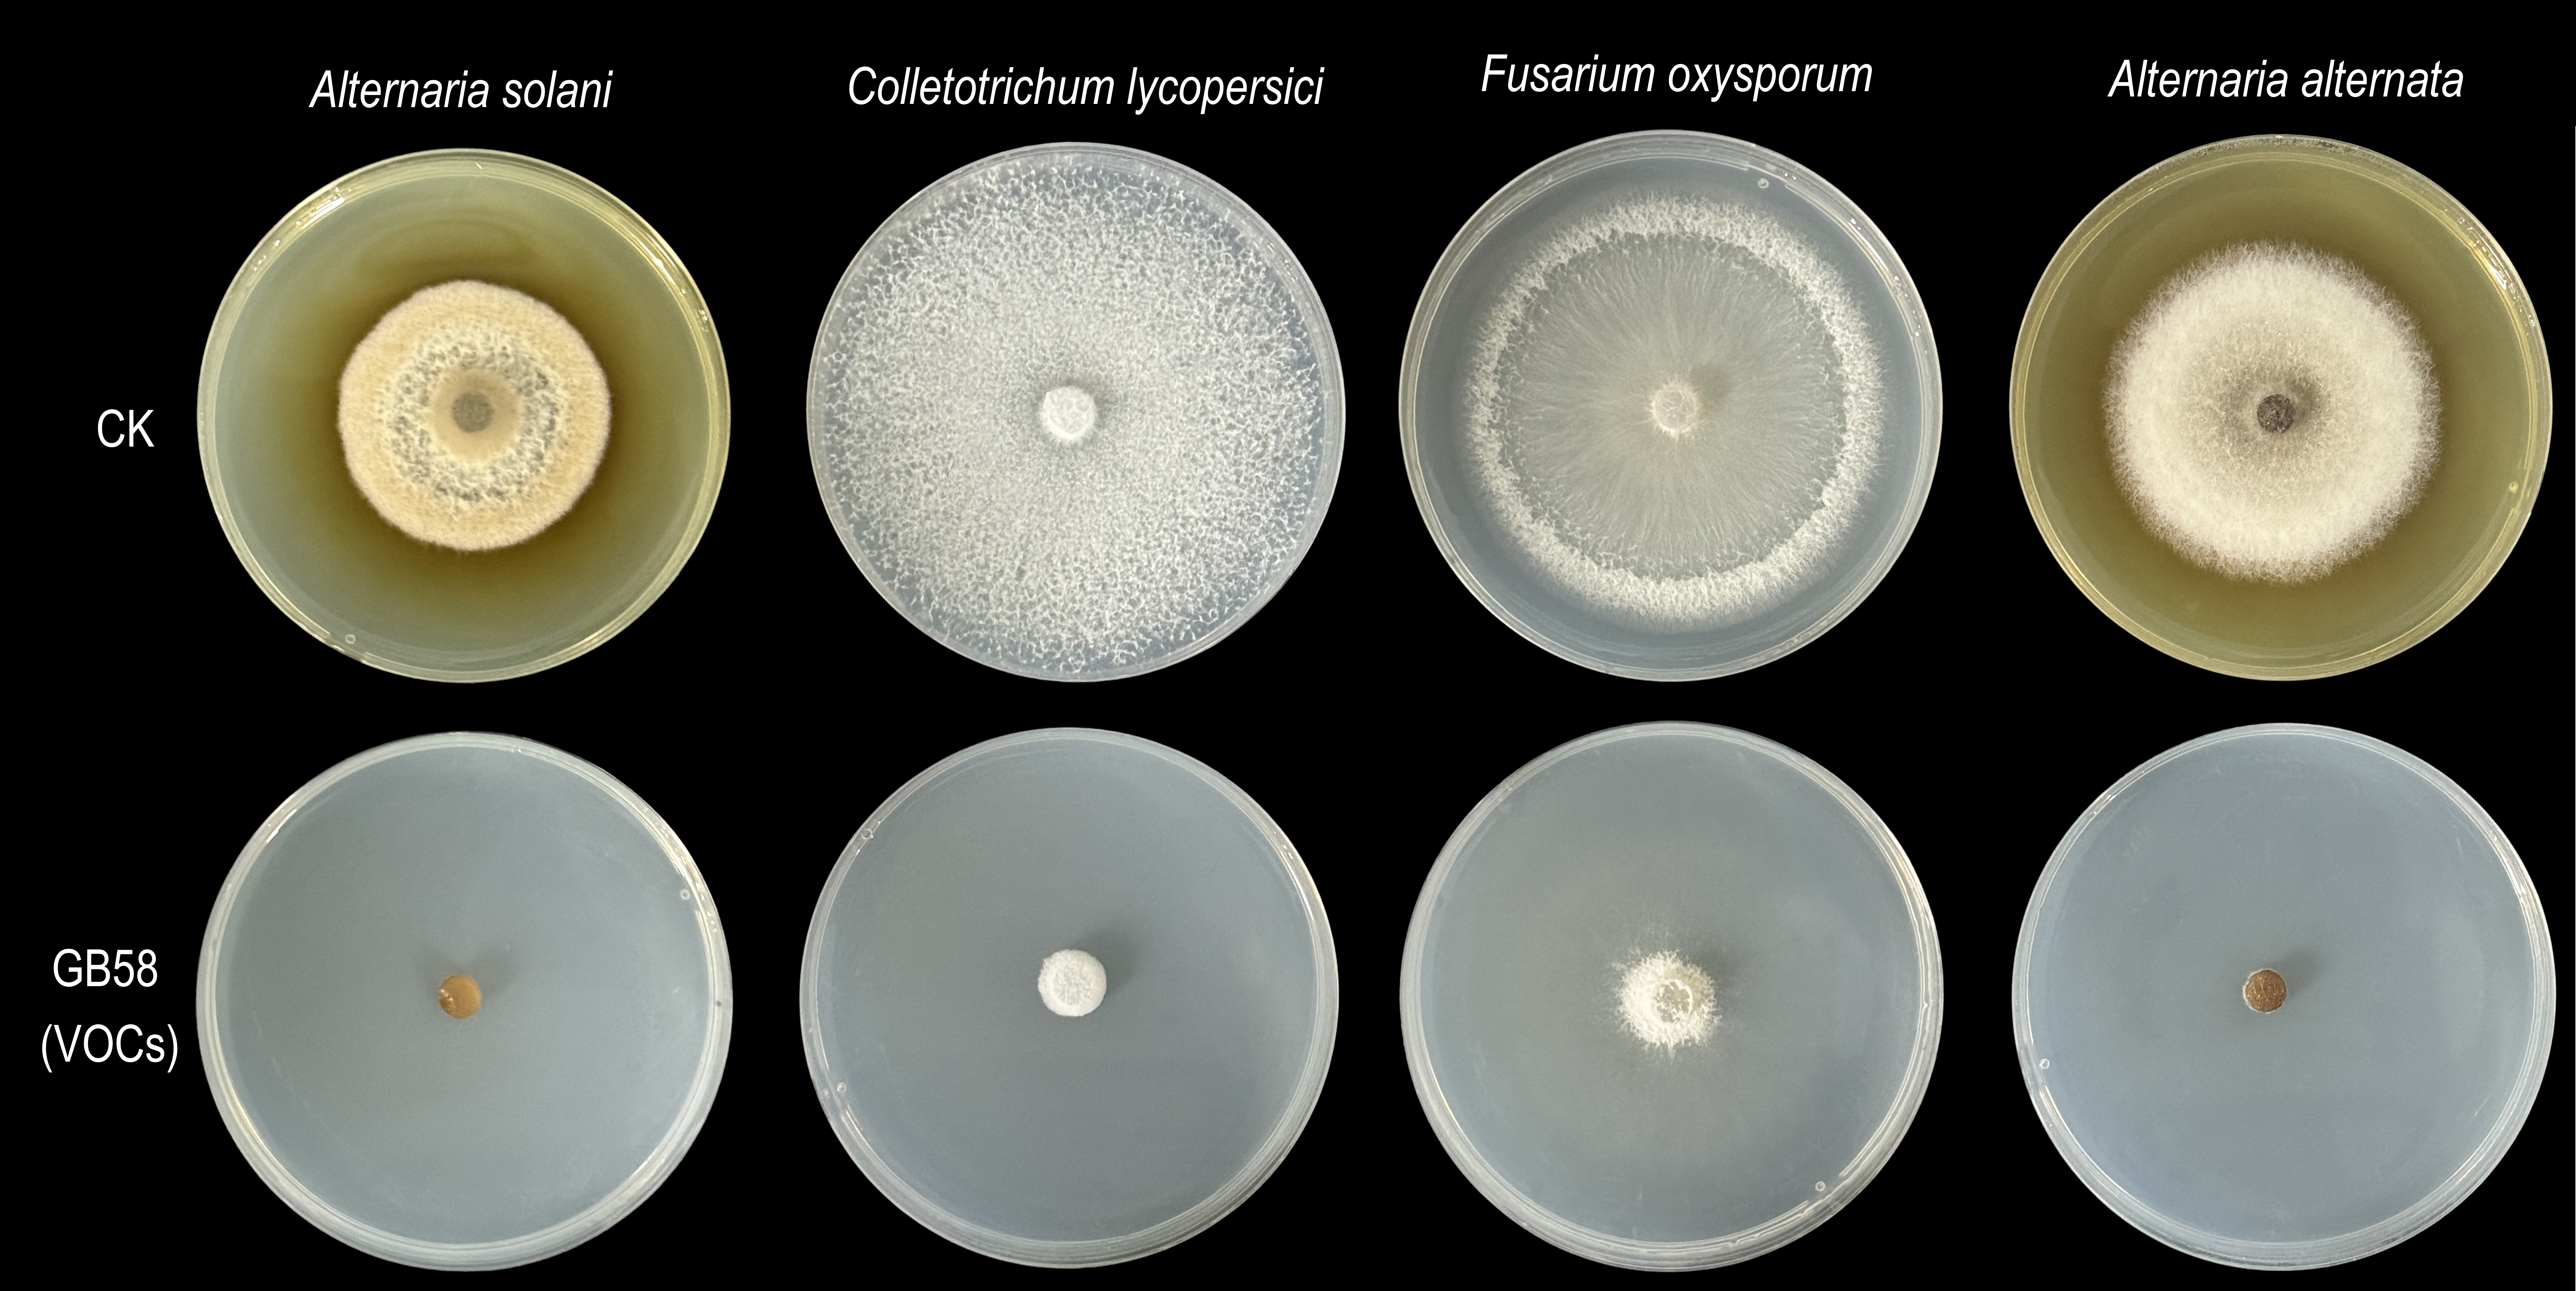

植物促生菌:
膠質類芽孢杆菌(Paenibacillus mucilaginosus)G78,該菌具有強大的溶磷效果,能夠幫助植物獲取土壤中難溶性磷元素,同時產生IAA以及胞外多糖等有益分子促進植物生長。


植物生防菌:
貝萊斯芽孢杆菌(Bacillus velezensis)01142和特基拉芽孢杆菌(Bacillus tequilensis)01137能夠分泌多種天然抗菌活性物質抑製植物病原菌的生長,其中對素有番茄“癌症”之稱的青枯病防控效果達到100%,顯著提高番茄免疫能力。


貝萊斯芽孢杆菌(Bacillus velezensis)GB58是一位“生防多麵手”,通過產生抗菌肽以及VOC能夠顯著抑製白菜炭疽病、番茄炭疽病、柑橘炭疽病、冬瓜枯萎病、香蕉枯萎病、番茄枯萎病、苦瓜枯萎病、番茄莖枯病、水稻紋枯病、水稻稻瘟病、馬鈴薯早疫病等10多種真菌病害。
環境處理功能菌:
廈門芽孢杆菌(Bacillus xiamenensis)BSM是一株有機汙染物降解菌,除草劑苄嘧磺隆經菌株處理7d後降解率可達90%,有效緩解除草劑對後茬作物的毒害的效應。
成都假單胞菌(Pseudomonas chengduensis)WD211是一株高效養殖汙水處理功能菌,魚塘養殖汙水經菌株WD211處理4天後,水體中氨氮、硝氮、總磷及COD等汙染物均下降60%-90%。

桔青黴(Penicillum citrinum PT1 ),是一株高效降解地膜的功能菌,能快速利用聚酯類生物降解地膜生長,35d地膜失重率達50%左右。
